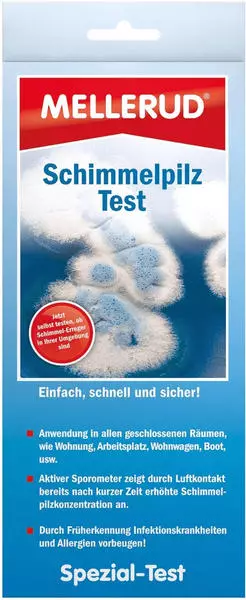

Schimmelpilz-Test Für Zuhause - Einfache Luftanalyse In 3 Schritten
Express-Zustellung mit DHL GoGreen , wenn Sie innerhalb der nächsten 24 Stunden
- 1-2 Werktage Lieferzeit
- Kostenloser Versand ab 34 €
- 30 Tage kostenloser Rückversand
Produktdetails
Schimmel im Haus? Mach den Check! Mit diesem aircheck Schimmelschnelltest findest du ganz einfach heraus, ob deine Raumluft belastet ist. In nur 3 Schritten zur Klarheit: Petrischale für 2 Stunden im Raum stehen lassen, dann 10 Tage bebrüten und anschließend die Schimmelkolonien zählen. Das Komplett-Set enthält alles, was du brauchst - inklusive ausführlicher Anleitung mit Tipps zur Schimmelvermeidung. Bereits nach 3 Tagen siehst du erste Ergebnisse. Wichtig: Vor dem Test 24 Stunden nicht lüften und Haustiere/Pflanzen aus dem Raum nehmen. Entwickelt in Deutschland - für ein gutes Gefühl in den eigenen vier Wänden. Kein Vorwissen nötig - einfach mal testen!
Produktmeinungen (850)
Hinweis zur Verifizierung
Eine Prüfung, ob diese Produktmeinungen von Verbrauchern stammen, die die bewertete Ware tatsächlich genutzt oder erworben haben, hat nicht stattgefunden, es sei denn die jeweilige Bewertung ist als „verifizierte Meinung” gekennzeichnet.
Mehr Informationen zum Verifizierungsprozess
Durchschnitt aus 850 Meinungen
Die Durchschnittsbewertung berechnet sich aus 578 Cimenio und 272 externen Meinungen.
Cimenio vergütet seine BewertendenWeitere Informationen
Qualität und Nachhaltigkeit
- Klimaneutrales Unternehmen
- Geprüftes Vergleichsportal